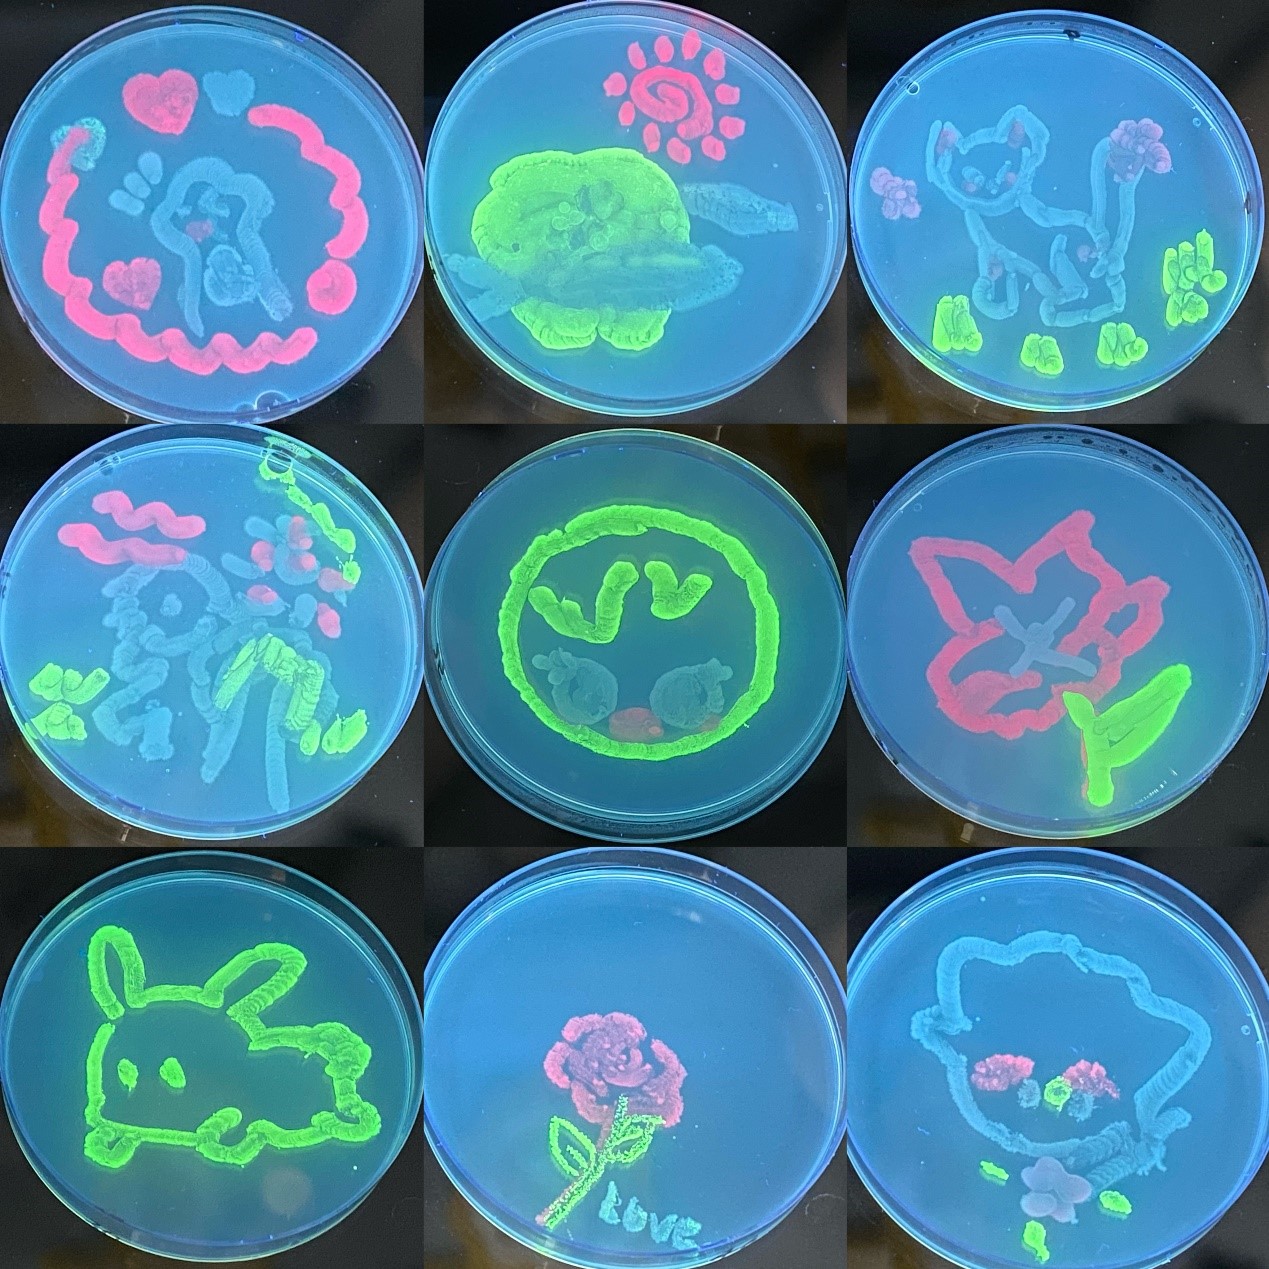

纸上得来终觉浅,绝知此事要躬行。为提高附中同学的科研热情与兴趣,丰富学生的课余生活,强化实验操作,培养学生创新思维和实践能力,7月5日及7月6日,西安交通大学生命学院教学实验中心迎来了西安交通大学附属中学高中部高一13班和初中部初二17班近100名同学,开展了以“生命之华——荧光微生物绘画”为主题的科普进中学校园活动。


本次活动是由生命学院教学实验中心举办的服务社会科普进校园系列活动之一,活动得到了生命学院教学实验中心和生命学院教工第一党支部各位老师的大力支持。活动由亓树艳老师组织,卢晓云教授,张雅利教授全程指导。谭丹副教授首先对同学们的到来表示热烈欢迎,并鼓励大家多了解科研、参与科研。亓树艳老师带领同学们参观了生命学院教学实验中心生物实验室。


随后,谭老师为同学们讲解了微生物对生产生活的重要作用和意义,帮助同学们从一个全新的角度对微生物进行认识;启发同学们思考如果有可能将微观世界直接呈现,是不是就可以暂时解锁显微镜的束缚?在其中,荧光蛋白是一把非常有用的钥匙。介绍了荧光蛋白的实验原理和操作步骤,鼓励学生们亲自操作、联想和发现,获得了生动有趣的平皿涂鸦作品,从中感受到实验探究的乐趣。实验活动也激发学生的科研兴趣,进一步提升学生科学素养。

同学们在实验过程中积极参与,热烈讨论。水母中不是有毒吗,怎样保证安全性?…..一系列有思考有深度的问题被同学们提出,生命学院张雅利教授耐心的给同学们进行解答。并且表示,参观实验室能够使得同学们在获得知识技能的同时,培养自身的生命科学基本素养及交叉创新的意识和能力,有利于将美育与智育融合,感受生命科学的独特魅力。期待更多同学们主动走进实验室,了解科研、参与科研,实现从知识学习者到知识创造者的转变!活动结束后同学们反响热烈,纷纷表示通过活动提升了生物学的素养,动手绘画的过程也使得实践能力得到大大的提高,感受到微生物的世界有趣而绚烂,大家的探索热情洋溢而热烈。